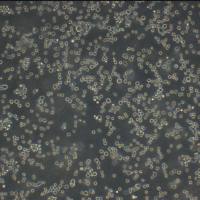
NCI-H1993 Cells人非小细胞肺癌腺癌细胞传代培养|STR图谱

相关产品推荐更多 >
万千商家帮你免费找货
0 人在求购买到急需产品
- 详细信息
- 文献和实验
- 技术资料
- 品系:
详见细胞说明资料
- 细胞类型:
详见细胞说明资料
- 肿瘤类型:
详见细胞说明资料
- 供应商:
上海冠导生物工程有限公司
- 库存:
≥100瓶
- 生长状态:
详见细胞说明资料
- 年限:
详见细胞说明资料
- 运输方式:
常温运输【复苏细胞】或干冰运输【冻存细胞】
- 器官来源:
详见细胞说明资料
- 是否是肿瘤细胞:
详见细胞说明资料
- 细胞形态:
详见细胞说明资料
- 免疫类型:
详见细胞说明资料
- 物种来源:
详见细胞说明资料
- 相关疾病:
详见细胞说明资料
- 组织来源:
详见细胞说明资料
- 英文名:
IMR-32人神经母细胞瘤细胞种子库|送STR图谱
- 规格:
1*10(6)Cellls/瓶
"IMR-32人神经母细胞瘤细胞种子库|送STR图谱
传代方法:1:2-1:4(首次传代建议1:2)
生长特性:贴壁生长
换液频率:每周2-3次
WAB0598 Cells(拥有STR基因鉴定图谱)
HG01871 Cells(拥有STR基因鉴定图谱)
HCC1395 Cells;背景说明:详见相关文献介绍;传代方法:1:2传代,每周换液2—3次;生长特性:贴壁生长;形态特性:上皮样;相关产品有:COLO-829 Cells、3T6 Cells、Human Fetal Thymocyte-8810 Cells
IMR-32人神经母细胞瘤细胞种子库|送STR图谱
背景资料:是一种人类神经母细胞瘤细胞系,来源于一名患有神经母细胞瘤的儿童患者的骨髓标本。神经母细胞瘤是一种起源于交感神经系统的恶性肿瘤,主要发生在儿童中。是由W·W·Nichols、J·Lee和S·Dwight于1967年4月从一位13个月大的男婴下腹部肿瘤中分离建系。诊断认为是神经母细胞瘤,并有少部分区域的器质性分化。
绝大部分细胞消化只要用胰酶润洗一遍即可:吸去胰酶后,残留的那些无法计算体积的附着在细胞表面的微量胰酶在37℃一般不到2min足够消化细胞(绝大部分1min不到)。对于这些细胞原则上不要用胰酶孵育细胞,连续这样传代,对细胞伤害很大。简单的程序是PBS润洗吸去,胰酶润洗吸去,然后37℃消化。什么算是消化好了呢?不需要把细胞全部消化成间隔分布很离散的单个圆形才算消化好了,一般你肉眼观察贴壁细胞层,只要能移动了,多半呈沙状移动,其实已经是可以了。一般能移动了,说明细胞与培养基质材料的附着已经消失了,细胞之间的附着也已经消失了,细胞已经独立分布了(虽然没有呈现很广的离散分布)。这个时候应该停止消化,不要等到看到镜下所有细胞都分离得非常好,间隙很大,才停止。细胞系在贴壁的过程中仍然会聚集,这个是贴壁培养的细胞,尤其是肿瘤细胞的一个特性,你可以尝试,准备100%的单个细胞悬液,贴壁后观察细胞,仍然是几个几个细胞聚集在一起。一些悬浮培养细胞也是如此,容易聚集,不要过几个小时就拿出来吹打成单细胞悬液。细胞只要能从基质上脱离下来,即使是成片的(比如Calu-3细胞),吹打不超过20次(一般10次即可),成小规模聚集(10个细胞左右)是正常的,不要再去延长消化时间,等待单细胞悬液出现。比较难消化的细胞:润洗方法5min还不能消化,以结肠癌细胞为例,比如:HCT15、LS411和KM12细胞,胰酶消化,一般10 cm培养皿,一次加入300ul-500ul就足够了。即使这样难消化的细胞,一般不超过5min,即可见细胞成片移动,就应该停止消化。一些正常细胞也会有难消化的时候,比如tsDC细胞,用胰酶孵育,3min左右即可看到成片沙状移动。
┈订┈购┈热┈线:1┈5┈8┈0┈0┈5┈7┈6┈8┈6┈7【微信同号】┈Q┈Q:3┈3┈0┈7┈2┈0┈4┈2┈7┈1;
产品包装形式:复苏细胞:T25培养瓶(一瓶)或冻存细胞:1ml冻存管(两支)
IMR-32人神经母细胞瘤细胞种子库|送STR图谱
上皮细胞(epithelial cell)是构成上皮组织的基本单位,广泛分布在人体的各个表面和体腔内,外胚层来源:皮肤、腺垂体、内耳膜、角膜、晶状体、鼻腔、口腔、肛门等处的上皮细胞由外胚层发育而来。中胚层来源:间皮、内皮等上皮细胞由中胚层发育而来。内胚层来源:中耳、呼吸道、肺、胸腺、消化道、消化腺、膀胱、阴道、甲状腺、甲状旁腺等处的上皮细胞由内胚层发育而来。许多癌症起源于上皮细胞,如肝细胞癌、结直肠癌、乳腺癌、肺癌、胃癌、前列腺癌、卵巢癌和子宫内膜癌。这些癌症中的上皮细胞通常表现出细胞标志物的变化,如E-cadherin的缺失和N-cadherin、vimentin等间充质细胞标志物的表达上调。
来源说明:细胞主要来源ATCC、DSMZ等细胞库
物种来源:Human\Mouse\Rat\Others
BNL 1MEA.7R.1 Cells;背景说明:肝;上皮细胞;BALB/c;传代方法:1:2-1:3传代;每周换液2-3次。;生长特性:贴壁;形态特性:详见产品说明书;相关产品有:CHO K1 Cells、SF17 Cells、NCTC 1469 Cells
Hepatoma 22 Cells;背景说明:1952年,前苏联医学科学院肿瘤研究所以C3HA小鼠诱发的H22肝癌实体瘤的瘤细胞悬液,昆明种小鼠皮下移植后,转腹水瘤。经检测,该瘤株在Km小鼠、615小鼠、C57BL/6小鼠、BALB/C小鼠体内可以形成实体瘤和腹水瘤。;传代方法:1:2-1:3传代;每周换液2-3次。;生长特性:悬浮;形态特性:淋巴母细胞;相关产品有:GM03190A Cells、NCI-H1563 Cells、OCILY-19 Cells
Roswell Park Memorial Institute 8402 Cells;背景说明:急性T淋巴细胞白血病;女性;传代方法:1:2-1:3传代;每周换液2-3次。;生长特性:悬浮;形态特性:详见产品说明书;相关产品有:Centre Antoine Lacassagne-39 Cells、NCI-H378 Cells、CAL-33 Cells
PIGI Cells;背景说明:皮肤;黑色素细胞;HPV16转化;男性;传代方法:1:2-1:3传代;每周换液2-3次。;生长特性:贴壁;形态特性:详见产品说明书;相关产品有:GTL 16 Cells、HS-683 Cells、Y3 Cells
┈订┈购┈热┈线:1┈5┈8┈0┈0┈5┈7┈6┈8┈6┈7【微信同号】┈Q┈Q:3┈3┈0┈7┈2┈0┈4┈2┈7┈1;
IMR-32人神经母细胞瘤细胞种子库|送STR图谱
形态特性:成纤维细胞样
如何进行细胞复苏:1)从容器中取出冻存管,直接浸入37℃温水中,并不时摇动令其尽快融化;2)从37℃水浴中取出冻存管,打开盖子,用吸管吸出细胞悬,加到离心管并滴加10倍以上培养,混匀;3)离心,1000rpm,5min;4)弃去上清,加入含10%小牛血清培养重悬细胞,计数,调整细胞密度,接种培养瓶,37℃培养箱静置培养;5)次日更换一次培养,继续培养。【温馨提醒】1)从增殖期到形成致密的单层细胞以前的培养细胞都可以用于冻存,但ZuiHAO为对数生长期细胞。在冻存前一天ZuiHAO换一次培养;2)将冻存管放入容器或从中取出时,要做HAO防护工作(戴棉手套),以免冻伤;3)冻存和复苏ZuiHAO用新配制的培养。细胞复苏的时候,有些初次实验员将冻存管从中取出后,放在室温下,经常发生冻存管爆炸,该怎么避免出现这种情况吗?其中在拧紧冻存管的时候是否有哪些细节要注意的?一般常用的方法是取出冻存管后在超净工作台中用酒精棉球擦试管口,再稍拧松盖子,再放37度水浴锅中摇溶,在将细胞转移到装有37度预热过的培养基的试管中,迅速离心,再用培养基洗一遍。
HuO9 Cells;背景说明:详见相关文献介绍;传代方法:1:2-1:3传代;每周换液2-3次。;生长特性:贴壁或悬浮,详见产品说明书部分;形态特性:详见产品说明书;相关产品有:SW1990 Cells、MDA-436 Cells、BT.549 Cells
H-1930 Cells;背景说明:详见相关文献介绍;传代方法:3-4天换液1次。;生长特性:悬浮生长;形态特性:详见产品说明书;相关产品有:PaCa2 Cells、HS-294-T Cells、253J-BV Cells
B16F10 Cells;背景说明:B16-F10是B16-F0的亚系。;传代方法:消化3-5分钟。1:2。3天内可长满。;生长特性:贴壁生长;形态特性:详见产品说明书;相关产品有:CFPAC Cells、SupB15WT Cells、NB1RGB Cells
PC3M-1E8 Cells;背景说明:前列腺癌;男性;传代方法:1:2-1:3传代;每周换液2-3次。;生长特性:贴壁;形态特性:详见产品说明书;相关产品有:CEMx721.174.T2 Cells、MC3T3-E1 Subclone 4 Cells、Hs839.T Cells
SW-962 Cells;背景说明:详见相关文献介绍;传代方法:1:3-1:6传代,2-3天换液1次。;生长特性:贴壁生长;形态特性:混合;相关产品有:H2126 Cells、Jiyoye (P-2003) Cells、CFPAC1 Cells
BLO11 Cells;背景说明:详见相关文献介绍;传代方法:1:2-1:3传代;每周换液2-3次。;生长特性:贴壁或悬浮,详见产品说明书部分;形态特性:详见产品说明书;相关产品有:H508 Cells、H522 Cells、C918 Cells
GM2219C Cells;背景说明:MOLT-4与MOLT-3来源于一名19岁的男性急性淋巴细胞性白血病的复发患者,该患者前期接受过多种药物联合化疗。MOLT-4细胞系为T淋巴细胞起源,p53基因的第248位密码子有一个G→A突变,不表达p53,不表达免疫球蛋白或EB病毒;可产生高水平的末端脱氧核糖转移酶;表达CD1(49%),CD2(35%),CD3A(26%)B(33%)C(34%),CD4(55%),CD5(72%),CD6(22%),CD7(77%)。;传代方法:1:2传代;生长特性:悬浮生长;形态特性:淋巴母细胞样;圆形;相关产品有:AK Cells、HEK 293-EBNA Cells、Loucy Cells
SNU878 Cells;背景说明:详见相关文献介绍;传代方法:1:2传代;生长特性:贴壁或悬浮,详见产品说明书部分;形态特性:详见产品说明书;相关产品有:L cell Cells、CMECs Cells、A-875 Cells
Tokyo Medical and Dental university 8 Cells;背景说明:弥漫大B淋巴瘤;男性;传代方法:1:2-1:3传代;每周换液2-3次。;生长特性:悬浮;形态特性:详见产品说明书;相关产品有:CEK Cells、HB 611 Cells、FLC-7 Cells
MARC145 Cells;背景说明:胚肾;自发永生;传代方法:1:2-1:3传代;每周换液2-3次。;生长特性:贴壁;形态特性:详见产品说明书;相关产品有:FRH-0201 Cells、IPLB-SF-21-AE Cells、HCC2157 Cells
ChaGo-K1 Cells;背景说明:详见相关文献介绍;传代方法:1:4-1:8传代;每周换液2次。;生长特性:贴壁生长;形态特性:上皮细胞;相关产品有:U-118 MG Cells、MDA-330 Cells、alpha TC1.6 Cells
UM-UC-14 Cells;背景说明:肾癌;男性;传代方法:1:2-1:3传代;每周换液2-3次。;生长特性:贴壁;形态特性:详见产品说明书;相关产品有:CF-1 MEF Cells、GL261 Cells、ZYM-DIEC02 Cells
SW260 Cells;背景说明:结肠癌;传代方法:1:2-1:3传代;每周换液2-3次。;生长特性:贴壁;形态特性:详见产品说明书;相关产品有:OVCAR-10 Cells、PLMVEC Cells、PG-4(S+L-) Cells
GM04679 Cells;背景说明:该细胞源自一名3岁患有Burkitt's淋巴瘤的黑人男孩的B淋巴细胞,EBNA阳性。;传代方法:1:2-1:4传代,每周2-3次。;生长特性:悬浮生长;形态特性:淋巴母细胞样;相关产品有:HEK-2 Cells、CO115 Cells、SK-RC-42 Cells
┈订┈购┈热┈线:1┈5┈8┈0┈0┈5┈7┈6┈8┈6┈7【微信同号】┈Q┈Q:3┈3┈0┈7┈2┈0┈4┈2┈7┈1;
MDA-MB-134 Cells;背景说明:该细胞1973年由R. Cailleau建系,源自74岁乳腺导管癌女性患者的胸腔积液,细胞生长缓慢,松散贴壁,生长过程中会脱落到培养基,不会汇合,过表达FGF受体;传代方法:1:2—1:4传代,每周换液2—3次;生长特性:松散贴壁生长;形态特性:上皮细胞样;相关产品有:OVCA432 Cells、Tu212 Cells、624-mel Cells
MKN 28 Cells;背景说明:详见相关文献介绍;传代方法:1:2-1:3传代;每周换液2-3次。;生长特性:贴壁或悬浮,详见产品说明书部分;形态特性:详见产品说明书;相关产品有:AG06814-N Cells、RPMI #1846 Cells、University of Michigan-Urothelial Carcinoma-1 Cells
SUIT-2 Cells;背景说明:胰腺管癌;男性;传代方法:1:2-1:3传代;每周换液2-3次。;生长特性:贴壁;形态特性:详见产品说明书;相关产品有:K1735 Cells、GalK 1 Cells、HLCL9B10 Cells
6-10B Cells(拥有STR基因鉴定图谱)
Abcam K-562 POLH KO Cells(拥有STR基因鉴定图谱)
AP48P(SVT)-1 Cells(拥有STR基因鉴定图谱)
BayGenomics ES cell line RRM028 Cells(拥有STR基因鉴定图谱)
BayGenomics ES cell line XN293 Cells(拥有STR基因鉴定图谱)
cAMP Hunter CHO-K1 GRM3 Gi Cells(拥有STR基因鉴定图谱)
DA00713 Cells(拥有STR基因鉴定图谱)
DA05423 Cells(拥有STR基因鉴定图谱)
GeneBLAzer Gqi5-NFAT-bla CHO-K1 Cells(拥有STR基因鉴定图谱)
IMR-32人神经母细胞瘤细胞种子库|送STR图谱
Ramos (RA 1) Cells;背景说明:详见相关文献介绍;传代方法:1:2-1:3传代;每周换液2-3次。;生长特性:贴壁或悬浮,详见产品说明书部分;形态特性:详见产品说明书;相关产品有:hESC Cells、K7M2 wt Cells、SW-1990 Cells
HCC1954 BL Cells;背景说明:外周血B淋巴细胞;EBV转化;女性;传代方法:1:2-1:3传代;每周换液2-3次。;生长特性:悬浮;形态特性:详见产品说明书;相关产品有:Sun Yat-sen university Ophtalmic center-Retinoblastoma 50 Cells、HPC-Y5 Cells、SW 900 Cells
WM115F Cells;背景说明:黑色素瘤;女性;传代方法:1:2-1:3传代;每周换液2-3次。;生长特性:贴壁;形态特性:详见产品说明书;相关产品有:WIL2S Cells、KPL-1 Cells、LLC PK1 Cells
Ca Ski Cells;背景说明:这株细胞是从小肠肠系膜转移灶的细胞中建立的。 据报道,它含有完整的HPV-16(每个细胞大约600个拷贝)和HPV-18相关序列。;传代方法:1:2传代;生长特性:贴壁生长;形态特性:上皮细胞样;相关产品有:Tb 1 Lu (NBL-12) Cells、University of Michigan-Urothelial Carcinoma-14 Cells、D-407 Cells
SNB.19 Cells;背景说明:详见相关文献介绍;传代方法:1:2传代;生长特性:贴壁生长 ;形态特性:详见产品说明书;相关产品有:LLC-MK2 Cells、Alpha Mouse Liver 12 Cells、KYSE-180 Cells
H2291 Cells;背景说明:详见相关文献介绍;传代方法:1:3-1:4传代;每周换液2-3次。;生长特性:贴壁生长;形态特性:上皮细胞样;相关产品有:RGC-6 Cells、H841 Cells、HCV-29 Cells
COLO 320HSR Cells;背景说明:该细胞1984年建系,源自一位33岁患有大肠腺癌男性经5-fu治疗后的腹水。;传代方法:1:2传代。3天内可长满。;生长特性:半贴壁生长;形态特性:详见产品说明书;相关产品有:A 72 Cells、OV90 Cells、HHL-5 Cells
QGP 1 Cells;背景说明:胰腺癌;男性;传代方法:1:2-1:3传代;每周换液2-3次。;生长特性:贴壁;形态特性:详见产品说明书;相关产品有:H-35 Cells、LTEPsm Cells、CATH.a Cells
MAC1 Cells;背景说明:皮肤T淋巴瘤;女性;传代方法:1:2-1:3传代;每周换液2-3次。;生长特性:悬浮;形态特性:详见产品说明书;相关产品有:MuM-2B Cells、HCC-1428 Cells、SACC-LM Cells
hs 68 Cells;背景说明:该细胞1969年由Owens RB建立。;传代方法:1:2传代;生长特性:贴壁生长 ;形态特性:详见产品说明书;相关产品有:MSB1 Cells、MOLP-2 Cells、RBL2H3 Cells
JHH-7 Cells;背景说明:详见相关文献介绍;传代方法:1:2-1:3传代;每周换液2-3次。;生长特性:贴壁或悬浮,详见产品说明书部分;形态特性:详见产品说明书;相关产品有:GM03671 Cells、Hs_578t Cells、HBE 135-E6E7 Cells
FAK+/+ Cells;背景说明:详见相关文献介绍;传代方法:1:4-1:8传代; ;生长特性:贴壁生长;形态特性:成纤维细胞;相关产品有:NCI-H1869 Cells、Melanoma 14 Cells、RD-ES Cells
HT 1080 Cells;背景说明:该细胞源自一名35岁患有纤维肉瘤的白人男性的结缔组织;ras+。;传代方法:1:4-1:8传代;2-3天换液1次。;生长特性:贴壁生长;形态特性:上皮样;相关产品有:KG1A Cells、SKNBE(2) Cells、RMG-1 Cells
1D4 [Mouse hybridoma against human AZGP1] Cells(拥有STR基因鉴定图谱)
RS411 Cells;背景说明:详见相关文献介绍;传代方法:每周2-3次;生长特性:悬浮生长;形态特性:成淋巴细胞;相关产品有:NT2-D1 Cells、LAN-5 Cells、HEK293-FT Cells
COLO-699 Cells;背景说明:详见相关文献介绍;传代方法:1:2-1:3传代;每周换液2-3次。;生长特性:贴壁或悬浮,详见产品说明书部分;形态特性:详见产品说明书;相关产品有:LI7 Cells、CMT-64 Cells、BSC-1 Cells
CAL-120 Cells;背景说明:详见相关文献介绍;传代方法:1:2-1:3传代;每周换液2-3次。;生长特性:贴壁或悬浮,详见产品说明书部分;形态特性:详见产品说明书;相关产品有:Ishikawa Cells、RAT2 Cells、MBT-2 Cells
NGEC Cells;背景说明:胃黏膜;上皮 Cells;传代方法:1:2-1:3传代;每周换液2-3次。;生长特性:贴壁;形态特性:详见产品说明书;相关产品有:Duke University 145 Cells、TCam-2 Cells、SF-763 Cells
L-Wnt3A Cells;背景说明:详见相关文献介绍;传代方法:1:2-1:3传代;每周换液2-3次。;生长特性:贴壁或悬浮,详见产品说明书部分;形态特性:详见产品说明书;相关产品有:Hk-2 Cells、Hs1.Tes Cells、MUGCHOR1 Cells
AN3 CA Cells;背景说明:AN3CA细胞建系于1964年。它衍生于子宫内膜癌患者淋巴结转移组织,具有癌细胞的基本特性,能在体外长期传代培养,接种实验动物产生明显肿瘤。但细胞的生物学特性及超微结构尚未深入研究,仅发现该细胞系促黑激素合成为阴性。细胞常用于人子宫内膜癌细胞生物学及其相关特性研究。;传代方法:1:2传代;生长特性:贴壁生长;形态特性:上皮样;相关产品有:BV-2 Cells、Ishikawa Cells、COLO 679 Cells
CCRF-SB Cells;背景说明:急性T淋巴细胞白血病;男性;传代方法:1:2-1:3传代;每周换液2-3次。;生长特性:悬浮;形态特性:详见产品说明书;相关产品有:RT-BM 1 Cells、NS1-1 Ag4.1 Cells、C12 Cells
COLO 357 Cells;背景说明:胰腺癌;女性;传代方法:1:2-1:3传代;每周换液2-3次。;生长特性:贴壁;形态特性:详见产品说明书;相关产品有:MB-49 Cells、PC 61-5-3 Cells、AR42J Cells
GM25350 Cells(拥有STR基因鉴定图谱)
HAP1 NPL (-) 2 Cells(拥有STR基因鉴定图谱)
Ra #1 Cells;背景说明:详见相关文献介绍;传代方法:1:2-1:3传代;每周换液2-3次。;生长特性:贴壁或悬浮,详见产品说明书部分;形态特性:详见产品说明书;相关产品有:PC-10 Cells、MDAMB157 Cells、H-1781 Cells
U373 Cells;背景说明:胶质瘤;男性;传代方法:1:2-1:3传代;每周换液2-3次。;生长特性:贴壁;形态特性:详见产品说明书;相关产品有:ASPC1 Cells、BIC1 Cells、Y-79 Cells
SGC996 Cells;背景说明:胆囊癌;女性;传代方法:1:2-1:3传代;每周换液2-3次。;生长特性:贴壁;形态特性:详见产品说明书;相关产品有:HEI-193 Cells、HDF-a Cells、SNU-407 Cells
Mc Ardle 7777 Cells;背景说明:肝癌;雌性;Buffalo;传代方法:1:2-1:3传代;每周换液2-3次。;生长特性:贴壁;形态特性:详见产品说明书;相关产品有:PLC-PRF-5 Cells、MBMEC Cells、SUDHL-6 Cells
AG06814-J Cells;背景说明:LeonardHayflick建系;有限传代细胞系;寿命为50±10代(倍增时间24h);来自妊娠3个月的正常胚胎肺组织。该细胞系是第一个用于人制备的人二倍体细胞;培养基中添加TNFα可以加快细胞生长。;传代方法:1:2-1:4传代;2-3天换液1次;生长特性:贴壁生长;形态特性:成纤维细胞样;相关产品有:BAC1.2F5 Cells、Pt K2 Cells、LWnt-3A Cells
UM-UC-14 Cells;背景说明:肾癌;男性;传代方法:1:2-1:3传代;每周换液2-3次。;生长特性:贴壁;形态特性:详见产品说明书;相关产品有:CF-1 MEF Cells、GL261 Cells、ZYM-DIEC02 Cells
293 F Cells;背景说明:详见相关文献介绍;传代方法:1:2传代;生长特性:贴壁生长;悬浮生长;形态特性:上皮细胞样;相关产品有:Huh-7.5.1 Cells、RS4-11 Cells、U87 Cells
MSTO-211 Cells;背景说明:MSTO-211H细胞株是1985年从一位肺二相间皮瘤患者的胸水中建株的。这个病人接受过多种药物联合前期化疗。MSTO-211H细胞具有高亲和力的EGF结合位点,并表达神经元特异性烯醇酶(NSE)及人绒毛膜促性腺激素(HCG)的α与β亚基。未检测到左旋多巴胺脱羧酶(DDC),邦巴辛与神经tensin。细胞过表达c-myc原癌基因,并没有观察到基因重排或扩增。V-src,v-abl,v-erbB,c-raf1,Ha-ras,Ki-ras,和N-ras的表达呈阳性。未检测到N-m;传代方法:消化3-5分钟。1:2。3天内可长满。;生长特性:贴壁生长;形态特性:成纤维细胞样;相关产品有:HSC2 Cells、TFK1 Cells、SK.MEL.2 Cells
Hs 198.Bl Cells(拥有STR基因鉴定图谱)
KM12-L4 Cells(拥有STR基因鉴定图谱)
ML-DmD23-c4 Cells(拥有STR基因鉴定图谱)
NS-5 Cells(拥有STR基因鉴定图谱)
RECC-KU45 Cells(拥有STR基因鉴定图谱)
Ubigene HCT 116 MAP3K4 KO Cells(拥有STR基因鉴定图谱)
PIGI Cells;背景说明:皮肤;黑色素细胞;HPV16转化;男性;传代方法:1:2-1:3传代;每周换液2-3次。;生长特性:贴壁;形态特性:详见产品说明书;相关产品有:GTL 16 Cells、HS-683 Cells、Y3 Cells
LC-2/ad Cells;背景说明:详见相关文献介绍;传代方法:1:2-1:3传代;每周换液2-3次。;生长特性:贴壁或悬浮,详见产品说明书部分;形态特性:详见产品说明书;相关产品有:TE-85 clone 5 Cells、SDBMSC Cells、AG 9 Cells
SC Cells;背景说明:急性单核细胞白血病;男性;传代方法:1:2-1:3传代;每周换液2-3次。;生长特性:悬浮;形态特性:详见产品说明书;相关产品有:DU145 Cells、HT 115 Cells、H87 Cells
Hs-343-T Cells;背景说明:详见相关文献介绍;传代方法:1:2—1:3传代;每周换液2-3次。;生长特性:贴壁生长;形态特性:成纤维细胞;相关产品有:FL83B Cells、RCK-8 Cells、HCT FET Cells
H-2122 Cells;背景说明:详见相关文献介绍;传代方法:1:3-1:4传代;每周换液2-3次。;生长特性:贴壁生长;形态特性:淋巴母细胞;相关产品有:SF126 Cells、MDA231-LM2-4175 Cells、TF1 Cells
PG-BE1 Cells;背景说明:肺巨细胞癌;传代方法:1:2-1:3传代;每周换液2-3次。;生长特性:贴壁;形态特性:详见产品说明书;相关产品有:H-1792 Cells、SUPT-1 Cells、H510A Cells
PK-13 Cells;背景说明:详见相关文献介绍;传代方法:1:2—1:4传代,每周换液2—3次;生长特性:贴壁生长;形态特性:上皮细胞样;相关产品有:PG-BE1 Cells、NCI H747 Cells、EBNA-293 Cells
COLO 320F Cells;背景说明:详见相关文献介绍;传代方法:1:2-1:3传代;每周换液2-3次。;生长特性:贴壁;形态特性:淋巴母细胞;相关产品有:G-402 Cells、IAR-20 Cells、Immortalized Human Hepatocytes Cells
MB-49 Cells;背景说明:膀胱癌;雄性;C57BL/Icrfa(t);传代方法:1:2-1:3传代;每周换液2-3次。;生长特性:贴壁;形态特性:详见产品说明书;相关产品有:HT29 Cells、KOPN-8 Cells、UC-3 Cells
Stanford University-Diffuse Histiocytic Lymphoma-2 Cells;背景说明:弥漫性大细胞淋巴瘤;胸腔积液转移;女性;传代方法:1:2-1:3传代;每周换液2-3次。;生长特性:悬浮;形态特性:详见产品说明书;相关产品有:Hep-3B Cells、KM12 SM Cells、HEK293E Cells
┈订┈购┈热┈线:1┈5┈8┈0┈0┈5┈7┈6┈8┈6┈7【微信同号】┈Q┈Q:3┈3┈0┈7┈2┈0┈4┈2┈7┈1;
STBCi077-B Cells(拥有STR基因鉴定图谱)
MB468 Cells;背景说明:该细胞是1977年由CailleauR等从一位患有转移性乳腺癌的51岁黑人女性的胸腔积液中分离得到的。虽然供体组织的G6PD等位基因杂合,但此细胞株始终表现为G6PDA表型。P53基因273位密码子存在G→A突变,从而导致Arg→His替代。每个细胞上存在1×106个EGF受体。;传代方法:1:2-1:4传代;2-3天换液1次;生长特性:贴壁生长;形态特性:上皮样;相关产品有:Pt-K2 Cells、BT325 Cells、HEK-293A Cells
P3/NS1/1-Ag4.1 Cells;背景说明:这是P3X63Ag8(ATCCTIB-9)的一个不分泌克隆。Kappa链合成了但不分泌。能抗0.1mM8-氮杂鸟嘌呤但不能在HAT培养基中生长。据报道它是由于缺失了3-酮类固醇还原酶活性的胆固醇营养缺陷型。检测表明肢骨发育畸形病毒(鼠痘)阴性。;传代方法:1:2传代,3天内可长满。;生长特性:悬浮生长;形态特性:淋巴母细胞;相关产品有:H2444 Cells、IR 983F Cells、LC1 Cells
IMR-32 Cells;背景说明:该细胞是1967年4月由NicholsWW,LeeJ和DwightS建立,来源于一名13月龄白人男婴腹部肿块,临床诊断为神经母细胞瘤,伴有极少部位的类器官样分化。;传代方法:1:2传代;生长特性:贴壁生长;形态特性:存在两种细胞类型,小的神经母细胞样细胞和大的透明成纤维样细胞;相关产品有:BpRcl Cells、SKNF1 Cells、Hs729T Cells
BEL 7405 Cells;背景说明:详见相关文献介绍;传代方法:1:2-1:3传代;每周换液2-3次。;生长特性:贴壁;形态特性:上皮细胞样;相关产品有:NCI-H128 Cells、D-341 Cells、IOSE80UBC Cells
Huh-7.5 Cells;背景说明:肝癌;男性;传代方法:1:2-1:3传代;每周换液2-3次。;生长特性:贴壁;形态特性:详见产品说明书;相关产品有:HEK 293-H Cells、NCI-H510 Cells、MA104 Cells
NCCIT Cells;背景说明:详见相关文献介绍;传代方法:1:4—1:8传代,每周换液2—3次;生长特性:贴壁生长;形态特性:上皮细胞;相关产品有:L-929 Cells、Ca Ski Cells、NPC-TW01 Cells
GM 2132 Cells;背景说明:来源于一位61岁的男性浆细胞瘤患者;可产生免疫球蛋白轻链,未检测到重链。;传代方法:按1:2传代,5-6小时可以看到细胞分裂;生长特性:悬浮生长;形态特性:淋巴母细胞样;相关产品有:GM04154B Cells、GI-1 Cells、EFM-192A Cells
BNL CL.2 Cells;背景说明:详见相关文献介绍;传代方法:1:2传代;生长特性:贴壁生长 ;形态特性:详见产品说明书;相关产品有:TF1 Cells、JURKAT E-6.1 Cells、Colo-206F Cells
HCC2279 Cells;背景说明:肺腺鳞癌细胞;女性;传代方法:1:2-1:3传代;每周换液2-3次。;生长特性:贴壁;形态特性:详见产品说明书;相关产品有:HuCC-T1 Cells、NCIH446 Cells、LIM-1215 Cells
OCILY10 Cells;背景说明:弥漫大B细胞淋巴瘤;传代方法:1:2-1:3传代;每周换液2-3次。;生长特性:悬浮;形态特性:详见产品说明书;相关产品有:HLF-a Cells、YD15 Cells、ROS-17/2.8 Cells
686LN-M4e Cells;背景说明:详见相关文献介绍;传代方法:1:2-1:3传代;每周换液2-3次。;生长特性:贴壁或悬浮,详见产品说明书部分;形态特性:详见产品说明书;相关产品有:HSC-2 Cells、16HBE140 Cells、Rca-B Cells
SUDHL2 Cells;背景说明:弥漫性大细胞淋巴瘤;胸腔积液转移;女性;传代方法:1:2-1:3传代;每周换液2-3次。;生长特性:悬浮;形态特性:详见产品说明书;相关产品有:L-M (TK-) Cells、OACP4C Cells、T98 Cells
M-O7e Cells;背景说明:详见相关文献介绍;传代方法:1:2-1:3传代;每周换液2-3次。;生长特性:贴壁或悬浮,详见产品说明书部分;形态特性:详见产品说明书;相关产品有:SV40-MES13 Cells、SK-MEL3 Cells、UMUC3 Cells
MEF Cells;背景说明:取孕9天的615小鼠胚胎,去除脑、心脏等培养建立。该细胞可用作饲养层细胞,支持胚胎干细胞ES的生长并维持ES未分化的状态。当作为饲养层细胞时,MEF需经处理停止生长。建议作为ES细胞的饲养层时,MEF不要超过6代。;传代方法:1:2传代;生长特性:贴壁生长;形态特性:成纤维细胞样;相关产品有:MCMEC Cells、B-95-8 Cells、RBL Cells
BayGenomics ES cell line RRA055 Cells(拥有STR基因鉴定图谱)
IMR-32人神经母细胞瘤细胞种子库|送STR图谱
BayGenomics ES cell line XE140 Cells(拥有STR基因鉴定图谱)
CRCBT-06-004 Cells(拥有STR基因鉴定图谱)
MESC 16 Cells(拥有STR基因鉴定图谱)
SN1b Cells(拥有STR基因鉴定图谱)
LPC-Aa98-19 Cells(拥有STR基因鉴定图谱)
"
传代方法:1:2-1:4(首次传代建议1:2)
生长特性:贴壁生长
换液频率:每周2-3次
WAB0598 Cells(拥有STR基因鉴定图谱)
HG01871 Cells(拥有STR基因鉴定图谱)
HCC1395 Cells;背景说明:详见相关文献介绍;传代方法:1:2传代,每周换液2—3次;生长特性:贴壁生长;形态特性:上皮样;相关产品有:COLO-829 Cells、3T6 Cells、Human Fetal Thymocyte-8810 Cells
IMR-32人神经母细胞瘤细胞种子库|送STR图谱
背景资料:是一种人类神经母细胞瘤细胞系,来源于一名患有神经母细胞瘤的儿童患者的骨髓标本。神经母细胞瘤是一种起源于交感神经系统的恶性肿瘤,主要发生在儿童中。是由W·W·Nichols、J·Lee和S·Dwight于1967年4月从一位13个月大的男婴下腹部肿瘤中分离建系。诊断认为是神经母细胞瘤,并有少部分区域的器质性分化。
绝大部分细胞消化只要用胰酶润洗一遍即可:吸去胰酶后,残留的那些无法计算体积的附着在细胞表面的微量胰酶在37℃一般不到2min足够消化细胞(绝大部分1min不到)。对于这些细胞原则上不要用胰酶孵育细胞,连续这样传代,对细胞伤害很大。简单的程序是PBS润洗吸去,胰酶润洗吸去,然后37℃消化。什么算是消化好了呢?不需要把细胞全部消化成间隔分布很离散的单个圆形才算消化好了,一般你肉眼观察贴壁细胞层,只要能移动了,多半呈沙状移动,其实已经是可以了。一般能移动了,说明细胞与培养基质材料的附着已经消失了,细胞之间的附着也已经消失了,细胞已经独立分布了(虽然没有呈现很广的离散分布)。这个时候应该停止消化,不要等到看到镜下所有细胞都分离得非常好,间隙很大,才停止。细胞系在贴壁的过程中仍然会聚集,这个是贴壁培养的细胞,尤其是肿瘤细胞的一个特性,你可以尝试,准备100%的单个细胞悬液,贴壁后观察细胞,仍然是几个几个细胞聚集在一起。一些悬浮培养细胞也是如此,容易聚集,不要过几个小时就拿出来吹打成单细胞悬液。细胞只要能从基质上脱离下来,即使是成片的(比如Calu-3细胞),吹打不超过20次(一般10次即可),成小规模聚集(10个细胞左右)是正常的,不要再去延长消化时间,等待单细胞悬液出现。比较难消化的细胞:润洗方法5min还不能消化,以结肠癌细胞为例,比如:HCT15、LS411和KM12细胞,胰酶消化,一般10 cm培养皿,一次加入300ul-500ul就足够了。即使这样难消化的细胞,一般不超过5min,即可见细胞成片移动,就应该停止消化。一些正常细胞也会有难消化的时候,比如tsDC细胞,用胰酶孵育,3min左右即可看到成片沙状移动。
┈订┈购┈热┈线:1┈5┈8┈0┈0┈5┈7┈6┈8┈6┈7【微信同号】┈Q┈Q:3┈3┈0┈7┈2┈0┈4┈2┈7┈1;
产品包装形式:复苏细胞:T25培养瓶(一瓶)或冻存细胞:1ml冻存管(两支)
IMR-32人神经母细胞瘤细胞种子库|送STR图谱
上皮细胞(epithelial cell)是构成上皮组织的基本单位,广泛分布在人体的各个表面和体腔内,外胚层来源:皮肤、腺垂体、内耳膜、角膜、晶状体、鼻腔、口腔、肛门等处的上皮细胞由外胚层发育而来。中胚层来源:间皮、内皮等上皮细胞由中胚层发育而来。内胚层来源:中耳、呼吸道、肺、胸腺、消化道、消化腺、膀胱、阴道、甲状腺、甲状旁腺等处的上皮细胞由内胚层发育而来。许多癌症起源于上皮细胞,如肝细胞癌、结直肠癌、乳腺癌、肺癌、胃癌、前列腺癌、卵巢癌和子宫内膜癌。这些癌症中的上皮细胞通常表现出细胞标志物的变化,如E-cadherin的缺失和N-cadherin、vimentin等间充质细胞标志物的表达上调。
来源说明:细胞主要来源ATCC、DSMZ等细胞库
物种来源:Human\Mouse\Rat\Others
BNL 1MEA.7R.1 Cells;背景说明:肝;上皮细胞;BALB/c;传代方法:1:2-1:3传代;每周换液2-3次。;生长特性:贴壁;形态特性:详见产品说明书;相关产品有:CHO K1 Cells、SF17 Cells、NCTC 1469 Cells
Hepatoma 22 Cells;背景说明:1952年,前苏联医学科学院肿瘤研究所以C3HA小鼠诱发的H22肝癌实体瘤的瘤细胞悬液,昆明种小鼠皮下移植后,转腹水瘤。经检测,该瘤株在Km小鼠、615小鼠、C57BL/6小鼠、BALB/C小鼠体内可以形成实体瘤和腹水瘤。;传代方法:1:2-1:3传代;每周换液2-3次。;生长特性:悬浮;形态特性:淋巴母细胞;相关产品有:GM03190A Cells、NCI-H1563 Cells、OCILY-19 Cells
Roswell Park Memorial Institute 8402 Cells;背景说明:急性T淋巴细胞白血病;女性;传代方法:1:2-1:3传代;每周换液2-3次。;生长特性:悬浮;形态特性:详见产品说明书;相关产品有:Centre Antoine Lacassagne-39 Cells、NCI-H378 Cells、CAL-33 Cells
PIGI Cells;背景说明:皮肤;黑色素细胞;HPV16转化;男性;传代方法:1:2-1:3传代;每周换液2-3次。;生长特性:贴壁;形态特性:详见产品说明书;相关产品有:GTL 16 Cells、HS-683 Cells、Y3 Cells
┈订┈购┈热┈线:1┈5┈8┈0┈0┈5┈7┈6┈8┈6┈7【微信同号】┈Q┈Q:3┈3┈0┈7┈2┈0┈4┈2┈7┈1;
IMR-32人神经母细胞瘤细胞种子库|送STR图谱
形态特性:成纤维细胞样
如何进行细胞复苏:1)从容器中取出冻存管,直接浸入37℃温水中,并不时摇动令其尽快融化;2)从37℃水浴中取出冻存管,打开盖子,用吸管吸出细胞悬,加到离心管并滴加10倍以上培养,混匀;3)离心,1000rpm,5min;4)弃去上清,加入含10%小牛血清培养重悬细胞,计数,调整细胞密度,接种培养瓶,37℃培养箱静置培养;5)次日更换一次培养,继续培养。【温馨提醒】1)从增殖期到形成致密的单层细胞以前的培养细胞都可以用于冻存,但ZuiHAO为对数生长期细胞。在冻存前一天ZuiHAO换一次培养;2)将冻存管放入容器或从中取出时,要做HAO防护工作(戴棉手套),以免冻伤;3)冻存和复苏ZuiHAO用新配制的培养。细胞复苏的时候,有些初次实验员将冻存管从中取出后,放在室温下,经常发生冻存管爆炸,该怎么避免出现这种情况吗?其中在拧紧冻存管的时候是否有哪些细节要注意的?一般常用的方法是取出冻存管后在超净工作台中用酒精棉球擦试管口,再稍拧松盖子,再放37度水浴锅中摇溶,在将细胞转移到装有37度预热过的培养基的试管中,迅速离心,再用培养基洗一遍。
HuO9 Cells;背景说明:详见相关文献介绍;传代方法:1:2-1:3传代;每周换液2-3次。;生长特性:贴壁或悬浮,详见产品说明书部分;形态特性:详见产品说明书;相关产品有:SW1990 Cells、MDA-436 Cells、BT.549 Cells
H-1930 Cells;背景说明:详见相关文献介绍;传代方法:3-4天换液1次。;生长特性:悬浮生长;形态特性:详见产品说明书;相关产品有:PaCa2 Cells、HS-294-T Cells、253J-BV Cells
B16F10 Cells;背景说明:B16-F10是B16-F0的亚系。;传代方法:消化3-5分钟。1:2。3天内可长满。;生长特性:贴壁生长;形态特性:详见产品说明书;相关产品有:CFPAC Cells、SupB15WT Cells、NB1RGB Cells
PC3M-1E8 Cells;背景说明:前列腺癌;男性;传代方法:1:2-1:3传代;每周换液2-3次。;生长特性:贴壁;形态特性:详见产品说明书;相关产品有:CEMx721.174.T2 Cells、MC3T3-E1 Subclone 4 Cells、Hs839.T Cells
SW-962 Cells;背景说明:详见相关文献介绍;传代方法:1:3-1:6传代,2-3天换液1次。;生长特性:贴壁生长;形态特性:混合;相关产品有:H2126 Cells、Jiyoye (P-2003) Cells、CFPAC1 Cells
BLO11 Cells;背景说明:详见相关文献介绍;传代方法:1:2-1:3传代;每周换液2-3次。;生长特性:贴壁或悬浮,详见产品说明书部分;形态特性:详见产品说明书;相关产品有:H508 Cells、H522 Cells、C918 Cells
GM2219C Cells;背景说明:MOLT-4与MOLT-3来源于一名19岁的男性急性淋巴细胞性白血病的复发患者,该患者前期接受过多种药物联合化疗。MOLT-4细胞系为T淋巴细胞起源,p53基因的第248位密码子有一个G→A突变,不表达p53,不表达免疫球蛋白或EB病毒;可产生高水平的末端脱氧核糖转移酶;表达CD1(49%),CD2(35%),CD3A(26%)B(33%)C(34%),CD4(55%),CD5(72%),CD6(22%),CD7(77%)。;传代方法:1:2传代;生长特性:悬浮生长;形态特性:淋巴母细胞样;圆形;相关产品有:AK Cells、HEK 293-EBNA Cells、Loucy Cells
SNU878 Cells;背景说明:详见相关文献介绍;传代方法:1:2传代;生长特性:贴壁或悬浮,详见产品说明书部分;形态特性:详见产品说明书;相关产品有:L cell Cells、CMECs Cells、A-875 Cells
Tokyo Medical and Dental university 8 Cells;背景说明:弥漫大B淋巴瘤;男性;传代方法:1:2-1:3传代;每周换液2-3次。;生长特性:悬浮;形态特性:详见产品说明书;相关产品有:CEK Cells、HB 611 Cells、FLC-7 Cells
MARC145 Cells;背景说明:胚肾;自发永生;传代方法:1:2-1:3传代;每周换液2-3次。;生长特性:贴壁;形态特性:详见产品说明书;相关产品有:FRH-0201 Cells、IPLB-SF-21-AE Cells、HCC2157 Cells
ChaGo-K1 Cells;背景说明:详见相关文献介绍;传代方法:1:4-1:8传代;每周换液2次。;生长特性:贴壁生长;形态特性:上皮细胞;相关产品有:U-118 MG Cells、MDA-330 Cells、alpha TC1.6 Cells
UM-UC-14 Cells;背景说明:肾癌;男性;传代方法:1:2-1:3传代;每周换液2-3次。;生长特性:贴壁;形态特性:详见产品说明书;相关产品有:CF-1 MEF Cells、GL261 Cells、ZYM-DIEC02 Cells
SW260 Cells;背景说明:结肠癌;传代方法:1:2-1:3传代;每周换液2-3次。;生长特性:贴壁;形态特性:详见产品说明书;相关产品有:OVCAR-10 Cells、PLMVEC Cells、PG-4(S+L-) Cells
GM04679 Cells;背景说明:该细胞源自一名3岁患有Burkitt's淋巴瘤的黑人男孩的B淋巴细胞,EBNA阳性。;传代方法:1:2-1:4传代,每周2-3次。;生长特性:悬浮生长;形态特性:淋巴母细胞样;相关产品有:HEK-2 Cells、CO115 Cells、SK-RC-42 Cells
┈订┈购┈热┈线:1┈5┈8┈0┈0┈5┈7┈6┈8┈6┈7【微信同号】┈Q┈Q:3┈3┈0┈7┈2┈0┈4┈2┈7┈1;
MDA-MB-134 Cells;背景说明:该细胞1973年由R. Cailleau建系,源自74岁乳腺导管癌女性患者的胸腔积液,细胞生长缓慢,松散贴壁,生长过程中会脱落到培养基,不会汇合,过表达FGF受体;传代方法:1:2—1:4传代,每周换液2—3次;生长特性:松散贴壁生长;形态特性:上皮细胞样;相关产品有:OVCA432 Cells、Tu212 Cells、624-mel Cells
MKN 28 Cells;背景说明:详见相关文献介绍;传代方法:1:2-1:3传代;每周换液2-3次。;生长特性:贴壁或悬浮,详见产品说明书部分;形态特性:详见产品说明书;相关产品有:AG06814-N Cells、RPMI #1846 Cells、University of Michigan-Urothelial Carcinoma-1 Cells
SUIT-2 Cells;背景说明:胰腺管癌;男性;传代方法:1:2-1:3传代;每周换液2-3次。;生长特性:贴壁;形态特性:详见产品说明书;相关产品有:K1735 Cells、GalK 1 Cells、HLCL9B10 Cells
6-10B Cells(拥有STR基因鉴定图谱)
Abcam K-562 POLH KO Cells(拥有STR基因鉴定图谱)
AP48P(SVT)-1 Cells(拥有STR基因鉴定图谱)
BayGenomics ES cell line RRM028 Cells(拥有STR基因鉴定图谱)
BayGenomics ES cell line XN293 Cells(拥有STR基因鉴定图谱)
cAMP Hunter CHO-K1 GRM3 Gi Cells(拥有STR基因鉴定图谱)
DA00713 Cells(拥有STR基因鉴定图谱)
DA05423 Cells(拥有STR基因鉴定图谱)
GeneBLAzer Gqi5-NFAT-bla CHO-K1 Cells(拥有STR基因鉴定图谱)
IMR-32人神经母细胞瘤细胞种子库|送STR图谱
Ramos (RA 1) Cells;背景说明:详见相关文献介绍;传代方法:1:2-1:3传代;每周换液2-3次。;生长特性:贴壁或悬浮,详见产品说明书部分;形态特性:详见产品说明书;相关产品有:hESC Cells、K7M2 wt Cells、SW-1990 Cells
HCC1954 BL Cells;背景说明:外周血B淋巴细胞;EBV转化;女性;传代方法:1:2-1:3传代;每周换液2-3次。;生长特性:悬浮;形态特性:详见产品说明书;相关产品有:Sun Yat-sen university Ophtalmic center-Retinoblastoma 50 Cells、HPC-Y5 Cells、SW 900 Cells
WM115F Cells;背景说明:黑色素瘤;女性;传代方法:1:2-1:3传代;每周换液2-3次。;生长特性:贴壁;形态特性:详见产品说明书;相关产品有:WIL2S Cells、KPL-1 Cells、LLC PK1 Cells
Ca Ski Cells;背景说明:这株细胞是从小肠肠系膜转移灶的细胞中建立的。 据报道,它含有完整的HPV-16(每个细胞大约600个拷贝)和HPV-18相关序列。;传代方法:1:2传代;生长特性:贴壁生长;形态特性:上皮细胞样;相关产品有:Tb 1 Lu (NBL-12) Cells、University of Michigan-Urothelial Carcinoma-14 Cells、D-407 Cells
SNB.19 Cells;背景说明:详见相关文献介绍;传代方法:1:2传代;生长特性:贴壁生长 ;形态特性:详见产品说明书;相关产品有:LLC-MK2 Cells、Alpha Mouse Liver 12 Cells、KYSE-180 Cells
H2291 Cells;背景说明:详见相关文献介绍;传代方法:1:3-1:4传代;每周换液2-3次。;生长特性:贴壁生长;形态特性:上皮细胞样;相关产品有:RGC-6 Cells、H841 Cells、HCV-29 Cells
COLO 320HSR Cells;背景说明:该细胞1984年建系,源自一位33岁患有大肠腺癌男性经5-fu治疗后的腹水。;传代方法:1:2传代。3天内可长满。;生长特性:半贴壁生长;形态特性:详见产品说明书;相关产品有:A 72 Cells、OV90 Cells、HHL-5 Cells
QGP 1 Cells;背景说明:胰腺癌;男性;传代方法:1:2-1:3传代;每周换液2-3次。;生长特性:贴壁;形态特性:详见产品说明书;相关产品有:H-35 Cells、LTEPsm Cells、CATH.a Cells
MAC1 Cells;背景说明:皮肤T淋巴瘤;女性;传代方法:1:2-1:3传代;每周换液2-3次。;生长特性:悬浮;形态特性:详见产品说明书;相关产品有:MuM-2B Cells、HCC-1428 Cells、SACC-LM Cells
hs 68 Cells;背景说明:该细胞1969年由Owens RB建立。;传代方法:1:2传代;生长特性:贴壁生长 ;形态特性:详见产品说明书;相关产品有:MSB1 Cells、MOLP-2 Cells、RBL2H3 Cells
JHH-7 Cells;背景说明:详见相关文献介绍;传代方法:1:2-1:3传代;每周换液2-3次。;生长特性:贴壁或悬浮,详见产品说明书部分;形态特性:详见产品说明书;相关产品有:GM03671 Cells、Hs_578t Cells、HBE 135-E6E7 Cells
FAK+/+ Cells;背景说明:详见相关文献介绍;传代方法:1:4-1:8传代; ;生长特性:贴壁生长;形态特性:成纤维细胞;相关产品有:NCI-H1869 Cells、Melanoma 14 Cells、RD-ES Cells
HT 1080 Cells;背景说明:该细胞源自一名35岁患有纤维肉瘤的白人男性的结缔组织;ras+。;传代方法:1:4-1:8传代;2-3天换液1次。;生长特性:贴壁生长;形态特性:上皮样;相关产品有:KG1A Cells、SKNBE(2) Cells、RMG-1 Cells
1D4 [Mouse hybridoma against human AZGP1] Cells(拥有STR基因鉴定图谱)
RS411 Cells;背景说明:详见相关文献介绍;传代方法:每周2-3次;生长特性:悬浮生长;形态特性:成淋巴细胞;相关产品有:NT2-D1 Cells、LAN-5 Cells、HEK293-FT Cells
COLO-699 Cells;背景说明:详见相关文献介绍;传代方法:1:2-1:3传代;每周换液2-3次。;生长特性:贴壁或悬浮,详见产品说明书部分;形态特性:详见产品说明书;相关产品有:LI7 Cells、CMT-64 Cells、BSC-1 Cells
CAL-120 Cells;背景说明:详见相关文献介绍;传代方法:1:2-1:3传代;每周换液2-3次。;生长特性:贴壁或悬浮,详见产品说明书部分;形态特性:详见产品说明书;相关产品有:Ishikawa Cells、RAT2 Cells、MBT-2 Cells
NGEC Cells;背景说明:胃黏膜;上皮 Cells;传代方法:1:2-1:3传代;每周换液2-3次。;生长特性:贴壁;形态特性:详见产品说明书;相关产品有:Duke University 145 Cells、TCam-2 Cells、SF-763 Cells
L-Wnt3A Cells;背景说明:详见相关文献介绍;传代方法:1:2-1:3传代;每周换液2-3次。;生长特性:贴壁或悬浮,详见产品说明书部分;形态特性:详见产品说明书;相关产品有:Hk-2 Cells、Hs1.Tes Cells、MUGCHOR1 Cells
AN3 CA Cells;背景说明:AN3CA细胞建系于1964年。它衍生于子宫内膜癌患者淋巴结转移组织,具有癌细胞的基本特性,能在体外长期传代培养,接种实验动物产生明显肿瘤。但细胞的生物学特性及超微结构尚未深入研究,仅发现该细胞系促黑激素合成为阴性。细胞常用于人子宫内膜癌细胞生物学及其相关特性研究。;传代方法:1:2传代;生长特性:贴壁生长;形态特性:上皮样;相关产品有:BV-2 Cells、Ishikawa Cells、COLO 679 Cells
CCRF-SB Cells;背景说明:急性T淋巴细胞白血病;男性;传代方法:1:2-1:3传代;每周换液2-3次。;生长特性:悬浮;形态特性:详见产品说明书;相关产品有:RT-BM 1 Cells、NS1-1 Ag4.1 Cells、C12 Cells
COLO 357 Cells;背景说明:胰腺癌;女性;传代方法:1:2-1:3传代;每周换液2-3次。;生长特性:贴壁;形态特性:详见产品说明书;相关产品有:MB-49 Cells、PC 61-5-3 Cells、AR42J Cells
GM25350 Cells(拥有STR基因鉴定图谱)
HAP1 NPL (-) 2 Cells(拥有STR基因鉴定图谱)
Ra #1 Cells;背景说明:详见相关文献介绍;传代方法:1:2-1:3传代;每周换液2-3次。;生长特性:贴壁或悬浮,详见产品说明书部分;形态特性:详见产品说明书;相关产品有:PC-10 Cells、MDAMB157 Cells、H-1781 Cells
U373 Cells;背景说明:胶质瘤;男性;传代方法:1:2-1:3传代;每周换液2-3次。;生长特性:贴壁;形态特性:详见产品说明书;相关产品有:ASPC1 Cells、BIC1 Cells、Y-79 Cells
SGC996 Cells;背景说明:胆囊癌;女性;传代方法:1:2-1:3传代;每周换液2-3次。;生长特性:贴壁;形态特性:详见产品说明书;相关产品有:HEI-193 Cells、HDF-a Cells、SNU-407 Cells
Mc Ardle 7777 Cells;背景说明:肝癌;雌性;Buffalo;传代方法:1:2-1:3传代;每周换液2-3次。;生长特性:贴壁;形态特性:详见产品说明书;相关产品有:PLC-PRF-5 Cells、MBMEC Cells、SUDHL-6 Cells
AG06814-J Cells;背景说明:LeonardHayflick建系;有限传代细胞系;寿命为50±10代(倍增时间24h);来自妊娠3个月的正常胚胎肺组织。该细胞系是第一个用于人制备的人二倍体细胞;培养基中添加TNFα可以加快细胞生长。;传代方法:1:2-1:4传代;2-3天换液1次;生长特性:贴壁生长;形态特性:成纤维细胞样;相关产品有:BAC1.2F5 Cells、Pt K2 Cells、LWnt-3A Cells
UM-UC-14 Cells;背景说明:肾癌;男性;传代方法:1:2-1:3传代;每周换液2-3次。;生长特性:贴壁;形态特性:详见产品说明书;相关产品有:CF-1 MEF Cells、GL261 Cells、ZYM-DIEC02 Cells
293 F Cells;背景说明:详见相关文献介绍;传代方法:1:2传代;生长特性:贴壁生长;悬浮生长;形态特性:上皮细胞样;相关产品有:Huh-7.5.1 Cells、RS4-11 Cells、U87 Cells
MSTO-211 Cells;背景说明:MSTO-211H细胞株是1985年从一位肺二相间皮瘤患者的胸水中建株的。这个病人接受过多种药物联合前期化疗。MSTO-211H细胞具有高亲和力的EGF结合位点,并表达神经元特异性烯醇酶(NSE)及人绒毛膜促性腺激素(HCG)的α与β亚基。未检测到左旋多巴胺脱羧酶(DDC),邦巴辛与神经tensin。细胞过表达c-myc原癌基因,并没有观察到基因重排或扩增。V-src,v-abl,v-erbB,c-raf1,Ha-ras,Ki-ras,和N-ras的表达呈阳性。未检测到N-m;传代方法:消化3-5分钟。1:2。3天内可长满。;生长特性:贴壁生长;形态特性:成纤维细胞样;相关产品有:HSC2 Cells、TFK1 Cells、SK.MEL.2 Cells
Hs 198.Bl Cells(拥有STR基因鉴定图谱)
KM12-L4 Cells(拥有STR基因鉴定图谱)
ML-DmD23-c4 Cells(拥有STR基因鉴定图谱)
NS-5 Cells(拥有STR基因鉴定图谱)
RECC-KU45 Cells(拥有STR基因鉴定图谱)
Ubigene HCT 116 MAP3K4 KO Cells(拥有STR基因鉴定图谱)
PIGI Cells;背景说明:皮肤;黑色素细胞;HPV16转化;男性;传代方法:1:2-1:3传代;每周换液2-3次。;生长特性:贴壁;形态特性:详见产品说明书;相关产品有:GTL 16 Cells、HS-683 Cells、Y3 Cells
LC-2/ad Cells;背景说明:详见相关文献介绍;传代方法:1:2-1:3传代;每周换液2-3次。;生长特性:贴壁或悬浮,详见产品说明书部分;形态特性:详见产品说明书;相关产品有:TE-85 clone 5 Cells、SDBMSC Cells、AG 9 Cells
SC Cells;背景说明:急性单核细胞白血病;男性;传代方法:1:2-1:3传代;每周换液2-3次。;生长特性:悬浮;形态特性:详见产品说明书;相关产品有:DU145 Cells、HT 115 Cells、H87 Cells
Hs-343-T Cells;背景说明:详见相关文献介绍;传代方法:1:2—1:3传代;每周换液2-3次。;生长特性:贴壁生长;形态特性:成纤维细胞;相关产品有:FL83B Cells、RCK-8 Cells、HCT FET Cells
H-2122 Cells;背景说明:详见相关文献介绍;传代方法:1:3-1:4传代;每周换液2-3次。;生长特性:贴壁生长;形态特性:淋巴母细胞;相关产品有:SF126 Cells、MDA231-LM2-4175 Cells、TF1 Cells
PG-BE1 Cells;背景说明:肺巨细胞癌;传代方法:1:2-1:3传代;每周换液2-3次。;生长特性:贴壁;形态特性:详见产品说明书;相关产品有:H-1792 Cells、SUPT-1 Cells、H510A Cells
PK-13 Cells;背景说明:详见相关文献介绍;传代方法:1:2—1:4传代,每周换液2—3次;生长特性:贴壁生长;形态特性:上皮细胞样;相关产品有:PG-BE1 Cells、NCI H747 Cells、EBNA-293 Cells
COLO 320F Cells;背景说明:详见相关文献介绍;传代方法:1:2-1:3传代;每周换液2-3次。;生长特性:贴壁;形态特性:淋巴母细胞;相关产品有:G-402 Cells、IAR-20 Cells、Immortalized Human Hepatocytes Cells
MB-49 Cells;背景说明:膀胱癌;雄性;C57BL/Icrfa(t);传代方法:1:2-1:3传代;每周换液2-3次。;生长特性:贴壁;形态特性:详见产品说明书;相关产品有:HT29 Cells、KOPN-8 Cells、UC-3 Cells
Stanford University-Diffuse Histiocytic Lymphoma-2 Cells;背景说明:弥漫性大细胞淋巴瘤;胸腔积液转移;女性;传代方法:1:2-1:3传代;每周换液2-3次。;生长特性:悬浮;形态特性:详见产品说明书;相关产品有:Hep-3B Cells、KM12 SM Cells、HEK293E Cells
┈订┈购┈热┈线:1┈5┈8┈0┈0┈5┈7┈6┈8┈6┈7【微信同号】┈Q┈Q:3┈3┈0┈7┈2┈0┈4┈2┈7┈1;
STBCi077-B Cells(拥有STR基因鉴定图谱)
MB468 Cells;背景说明:该细胞是1977年由CailleauR等从一位患有转移性乳腺癌的51岁黑人女性的胸腔积液中分离得到的。虽然供体组织的G6PD等位基因杂合,但此细胞株始终表现为G6PDA表型。P53基因273位密码子存在G→A突变,从而导致Arg→His替代。每个细胞上存在1×106个EGF受体。;传代方法:1:2-1:4传代;2-3天换液1次;生长特性:贴壁生长;形态特性:上皮样;相关产品有:Pt-K2 Cells、BT325 Cells、HEK-293A Cells
P3/NS1/1-Ag4.1 Cells;背景说明:这是P3X63Ag8(ATCCTIB-9)的一个不分泌克隆。Kappa链合成了但不分泌。能抗0.1mM8-氮杂鸟嘌呤但不能在HAT培养基中生长。据报道它是由于缺失了3-酮类固醇还原酶活性的胆固醇营养缺陷型。检测表明肢骨发育畸形病毒(鼠痘)阴性。;传代方法:1:2传代,3天内可长满。;生长特性:悬浮生长;形态特性:淋巴母细胞;相关产品有:H2444 Cells、IR 983F Cells、LC1 Cells
IMR-32 Cells;背景说明:该细胞是1967年4月由NicholsWW,LeeJ和DwightS建立,来源于一名13月龄白人男婴腹部肿块,临床诊断为神经母细胞瘤,伴有极少部位的类器官样分化。;传代方法:1:2传代;生长特性:贴壁生长;形态特性:存在两种细胞类型,小的神经母细胞样细胞和大的透明成纤维样细胞;相关产品有:BpRcl Cells、SKNF1 Cells、Hs729T Cells
BEL 7405 Cells;背景说明:详见相关文献介绍;传代方法:1:2-1:3传代;每周换液2-3次。;生长特性:贴壁;形态特性:上皮细胞样;相关产品有:NCI-H128 Cells、D-341 Cells、IOSE80UBC Cells
Huh-7.5 Cells;背景说明:肝癌;男性;传代方法:1:2-1:3传代;每周换液2-3次。;生长特性:贴壁;形态特性:详见产品说明书;相关产品有:HEK 293-H Cells、NCI-H510 Cells、MA104 Cells
NCCIT Cells;背景说明:详见相关文献介绍;传代方法:1:4—1:8传代,每周换液2—3次;生长特性:贴壁生长;形态特性:上皮细胞;相关产品有:L-929 Cells、Ca Ski Cells、NPC-TW01 Cells
GM 2132 Cells;背景说明:来源于一位61岁的男性浆细胞瘤患者;可产生免疫球蛋白轻链,未检测到重链。;传代方法:按1:2传代,5-6小时可以看到细胞分裂;生长特性:悬浮生长;形态特性:淋巴母细胞样;相关产品有:GM04154B Cells、GI-1 Cells、EFM-192A Cells
BNL CL.2 Cells;背景说明:详见相关文献介绍;传代方法:1:2传代;生长特性:贴壁生长 ;形态特性:详见产品说明书;相关产品有:TF1 Cells、JURKAT E-6.1 Cells、Colo-206F Cells
HCC2279 Cells;背景说明:肺腺鳞癌细胞;女性;传代方法:1:2-1:3传代;每周换液2-3次。;生长特性:贴壁;形态特性:详见产品说明书;相关产品有:HuCC-T1 Cells、NCIH446 Cells、LIM-1215 Cells
OCILY10 Cells;背景说明:弥漫大B细胞淋巴瘤;传代方法:1:2-1:3传代;每周换液2-3次。;生长特性:悬浮;形态特性:详见产品说明书;相关产品有:HLF-a Cells、YD15 Cells、ROS-17/2.8 Cells
686LN-M4e Cells;背景说明:详见相关文献介绍;传代方法:1:2-1:3传代;每周换液2-3次。;生长特性:贴壁或悬浮,详见产品说明书部分;形态特性:详见产品说明书;相关产品有:HSC-2 Cells、16HBE140 Cells、Rca-B Cells
SUDHL2 Cells;背景说明:弥漫性大细胞淋巴瘤;胸腔积液转移;女性;传代方法:1:2-1:3传代;每周换液2-3次。;生长特性:悬浮;形态特性:详见产品说明书;相关产品有:L-M (TK-) Cells、OACP4C Cells、T98 Cells
M-O7e Cells;背景说明:详见相关文献介绍;传代方法:1:2-1:3传代;每周换液2-3次。;生长特性:贴壁或悬浮,详见产品说明书部分;形态特性:详见产品说明书;相关产品有:SV40-MES13 Cells、SK-MEL3 Cells、UMUC3 Cells
MEF Cells;背景说明:取孕9天的615小鼠胚胎,去除脑、心脏等培养建立。该细胞可用作饲养层细胞,支持胚胎干细胞ES的生长并维持ES未分化的状态。当作为饲养层细胞时,MEF需经处理停止生长。建议作为ES细胞的饲养层时,MEF不要超过6代。;传代方法:1:2传代;生长特性:贴壁生长;形态特性:成纤维细胞样;相关产品有:MCMEC Cells、B-95-8 Cells、RBL Cells
BayGenomics ES cell line RRA055 Cells(拥有STR基因鉴定图谱)
IMR-32人神经母细胞瘤细胞种子库|送STR图谱
BayGenomics ES cell line XE140 Cells(拥有STR基因鉴定图谱)
CRCBT-06-004 Cells(拥有STR基因鉴定图谱)
MESC 16 Cells(拥有STR基因鉴定图谱)
SN1b Cells(拥有STR基因鉴定图谱)
LPC-Aa98-19 Cells(拥有STR基因鉴定图谱)
"
风险提示:丁香通仅作为第三方平台,为商家信息发布提供平台空间。用户咨询产品时请注意保护个人信息及财产安全,合理判断,谨慎选购商品,商家和用户对交易行为负责。对于医疗器械类产品,请先查证核实企业经营资质和医疗器械产品注册证情况。
文献和实验该产品被引用文献
"PubMed=71759; DOI=10.1126/science.71759
Balaban-Malenbaum G.B., Gilbert F.
Double minute chromosomes and the homogeneously staining regions in chromosomes of a human neuroblastoma cell line.
Science 198:739-741(1977)
PubMed=327080; DOI=10.1093/jnci/59.1.221
Fogh J., Fogh J.M., Orfeo T.
One hundred and twenty-seven cultured human tumor cell lines producing tumors in nude mice.
J. Natl. Cancer Inst. 59:221-226(1977)
PubMed=833871; DOI=10.1093/jnci/58.2.209
Fogh J., Wright W.C., Loveless J.D.
Absence of HeLa cell contamination in 169 cell lines derived from human tumors.
J. Natl. Cancer Inst. 58:209-214(1977)
PubMed=922665; DOI=10.1002/1097-0142(197711)40:5<2256::AID-CNCR2820400536>3.0.CO;2-1
Brodeur G.M., Sekhon G.S., Goldstein M.N.
Chromosomal aberrations in human neuroblastomas.
Cancer 40:2256-2263(1977)
CLPUB00387
Coriell L.L., Greene A.E., Mulivor R.A.
The human genetic mutant cell repository: list of genetic variants, chromosomal aberrations and normal cell cultures submitted to the repository. 7th edition. October 1980.
(In misc. document) Institute for Medical Research (Camden, N.J.) NIH 80-2011; pp.1-254; National Institutes of Health; Bethesda; USA (1980)
PubMed=6935474; DOI=10.1093/jnci/66.2.239
Wright W.C., Daniels W.P., Fogh J.
Distinction of seventy-one cultured human tumor cell lines by polymorphic enzyme analysis.
J. Natl. Cancer Inst. 66:239-247(1981)
PubMed=7253718; DOI=10.1016/0047-6374(81)90027-0
Das N.K., Murphy D.G.
The National Institute on Aging repository cell cultures.
Mech. Ageing Dev. 16:1-17(1981)
PubMed=7459858
Rousset M., Zweibaum A., Fogh J.
Presence of glycogen and growth-related variations in 58 cultured human tumor cell lines of various tissue origins.
Cancer Res. 41:1165-1170(1981)
PubMed=7037175
Reynolds C.P., Reynolds D.A., Frenkel E.P., Smith R.G.
Selective toxicity of 6-hydroxydopamine and ascorbate for human neuroblastoma in vitro: a model for clearing marrow prior to autologous transplant.
Cancer Res. 42:1331-1336(1982)
PubMed=7139592; DOI=10.1016/0165-4608(82)90105-4
Gilbert F., Balaban-Malenbaum G.B., Moorhead P.S., Bianchi D., Schlesinger H.R.
Abnormalities of chromosome 1p in human neuroblastoma tumors and cell lines.
Cancer Genet. Cytogenet. 7:33-42(1982)
DOI=10.1016/B978-0-12-008304-6.50015-4
Biedler J.L., Meyers M.B., Spengler B.A.
Homogeneously staining regions and double minute chromosomes, prevalent cytogenetic abnormalities of human neuroblastoma cells.
(In book chapter) Advances in cellular neurobiology, Vol. 4; Fedoroff S., Hertz L. (eds.); pp.267-307; Academic Press; New York; USA (1983)
PubMed=6401685; DOI=10.1007/BF02617989
Halton D.M., Peterson W.D. Jr., Hukku B.
Cell culture quality control by rapid isoenzymatic characterization.
In Vitro 19:16-24(1983)
PubMed=6888561; DOI=10.1038/305245a0
Schwab M., Alitalo K., Klempnauer K.-H., Varmus H.E., Bishop J.M., Gilbert F., Brodeur G.M., Goldstein M.N., Trent J.M.
Amplified DNA with limited homology to myc cellular oncogene is shared by human neuroblastoma cell lines and a neuroblastoma tumour.
Nature 305:245-248(1983)
PubMed=3518877; DOI=10.3109/07357908609038260
Fogh J.
Human tumor lines for cancer research.
Cancer Invest. 4:157-184(1986)
PubMed=3698005
Bregman M.D., Funk C., Fukushima M.
Inhibition of human melanoma growth by prostaglandin A, D, and J analogues.
Cancer Res. 46:2740-2744(1986)
PubMed=2535691
Ciccarone V.C., Spengler B.A., Meyers M.B., Biedler J.L., Ross R.A.
Phenotypic diversification in human neuroblastoma cells: expression of distinct neural crest lineages.
Cancer Res. 49:219-225(1989)
PubMed=8221663
Komuro H., Hayashi Y., Kawamura M., Hayashi K., Kaneko Y., Kamoshita S., Hanada R., Yamamoto K., Hongo T., Yamada M., Tsuchida Y.
Mutations of the p53 gene are involved in Ewing's sarcomas but not in neuroblastomas.
Cancer Res. 53:5284-5288(1993)
PubMed=8490657; DOI=10.1038/ng0193-62
The I., Murthy A.E., Hannigan G.E., Jacoby L.B., Menon A.G., Gusella J.F., Bernards A.
Neurofibromatosis type 1 gene mutations in neuroblastoma.
Nat. Genet. 3:62-66(1993)
DOI=10.1016/B978-0-12-333530-2.50006-X
Israel M.A., Thiele C.J.
Tumor cell lines of the peripheral nervous system.
(In book chapter) Atlas of human tumor cell lines; Hay R.J., Park J.-G., Gazdar A.F. (eds.); pp.43-78; Academic Press; New York; USA (1994)
PubMed=7838528
Cheng N.C., Van Roy N., Chan A., Beitsma M., Westerveld A., Speleman F., Versteeg R.
Deletion mapping in neuroblastoma cell lines suggests two distinct tumor suppressor genes in the 1p35-36 region, only one of which is associated with N-myc amplification.
Oncogene 10:291-297(1995)
PubMed=8665486; DOI=10.1016/0304-3835(96)04250-4
Diccianni M.B., Chau L.S., Batova A., Vu T.Q., Yu A.L.-T.
The p16 and p18 tumor suppressor genes in neuroblastoma: implications for drug resistance.
Cancer Lett. 104:183-192(1996)
PubMed=9201287
Cinatl J. Jr., Hernaiz Driever P., Cinatl J., Ruckert D.G., Gumbel H.O.C., Rabenau H.F., Kornhuber B., Doerr H.-W.
Increased efficacy of aphidicolin killing of human neuroblastoma cells in vitro by encapsulation in liposomes.
Neoplasma 44:91-95(1997)
PubMed=9283597; DOI=10.1016/S0165-4608(96)00362-7
Van Roy N., Jauch A., Van Gele M., Laureys G., Versteeg R., De Paepe A., Cremer T., Speleman F.
Comparative genomic hybridization analysis of human neuroblastomas: detection of distal 1p deletions and further molecular genetic characterization of neuroblastoma cell lines.
Cancer Genet. Cytogenet. 97:135-142(1997)
PubMed=9516836; DOI=10.1016/S0959-8049(97)00319-5
Van Roy N., Laureys G., Van Gele M., Opdenakker G., Miura R., van der Drift P., Chan A., Versteeg R., Speleman F.
Analysis of 1;17 translocation breakpoints in neuroblastoma: implications for mapping of neuroblastoma genes.
Eur. J. Cancer 33:1974-1978(1997)
DOI=10.1007/0-306-46872-7_2
Thiele C.J.
Neuroblastoma.
(In book chapter) Human cell culture. Vol. 1. Cancer cell lines part 1; Masters J.R.W., Palsson B.O. (eds.); pp.21-53; Kluwer Academic Publishers; New York; USA (1999)
PubMed=11550280; DOI=10.1002/gcc.1174
Van Roy N., Van Limbergen H., Vandesompele J., Van Gele M., Poppe B., Salwen H.R., Laureys G., Manoel N., De Paepe A., Speleman F.
Combined M-FISH and CGH analysis allows comprehensive description of genetic alterations in neuroblastoma cell lines.
Genes Chromosomes Cancer 32:126-135(2001)
PubMed=11668190; DOI=10.1177/002215540104901105
Quentmeier H., Osborn M., Reinhardt J., Zaborski M., Drexler H.G.
Immunocytochemical analysis of cell lines derived from solid tumors.
J. Histochem. Cytochem. 49:1369-1378(2001)
PubMed=12210830; DOI=10.1002/jnr.10330
Yoshida S., Narita T., Taga T., Ohta S., Takeuchi Y.
Malignant rhabdoid tumor shows incomplete neural characteristics as revealed by expression of SNARE complex.
J. Neurosci. Res. 69:642-652(2002)
PubMed=12702577
Saito-Ohara F., Imoto I., Inoue J., Hosoi H., Nakagawara A., Sugimoto T., Inazawa J.
PPM1D is a potential target for 17q gain in neuroblastoma.
Cancer Res. 63:1876-1883(2003)
PubMed=15390183; DOI=10.1002/gcc.20096
Gebauer S., Yu A.L.-T., Omura-Minamisawa M., Batova A., Diccianni M.B.
Expression profiles and clinical relationships of ID2, CDKN1B, and CDKN2A in primary neuroblastoma.
Genes Chromosomes Cancer 41:297-308(2004)
PubMed=15892104; DOI=10.1002/gcc.20198
Mosse Y.P., Greshock J., Margolin A.A., Naylor T., Cole K.A., Khazi D., Hii G., Winter C., Shahzad S., Asziz M.U., Biegel J.A., Weber B.L., Maris J.M.
High-resolution detection and mapping of genomic DNA alterations in neuroblastoma.
Genes Chromosomes Cancer 43:390-403(2005)
PubMed=16524757; DOI=10.1016/j.biocel.2006.01.007
Fry D.G., Dayton B.D., Brodjian S.J., Ogiela C., Sidorowicz H., Frost L.J., McNally T., Reilly R.M., Collins C.A.
Characterization of a neuronal cell line expressing native human melanin-concentrating hormone receptor 1 (MCHR1).
Int. J. Biochem. Cell Biol. 38:1290-1299(2006)
PubMed=16822308; DOI=10.1186/1471-2407-6-177; PMCID=PMC1533846
Dam V., Morgan B.T., Mazanek P., Hogarty M.D.
Mutations in PIK3CA are infrequent in neuroblastoma.
BMC Cancer 6:177.1-177.10(2006)
PubMed=17974978; DOI=10.1158/0008-5472.CAN-06-4345
Xue C.-Y., Haber M., Flemming C., Marshall G.M., Lock R.B., MacKenzie K.L., Gurova K.V., Norris M.D., Gudkov A.V.
p53 determines multidrug sensitivity of childhood neuroblastoma.
Cancer Res. 67:10351-10360(2007)
PubMed=20655465; DOI=10.1016/j.cell.2010.06.004; PMCID=PMC2913027
Holzel M., Huang S.-D., Koster J., Ora I., Lakeman A., Caron H.N., Nijkamp W., Xie J., Callens T., Asgharzadeh S., Seeger R.C., Messiaen L.M., Versteeg R., Bernards R.
NF1 is a tumor suppressor in neuroblastoma that determines retinoic acid response and disease outcome.
Cell 142:218-229(2010)
PubMed=22213050; DOI=10.1002/ijc.27415; PMCID=PMC3757132
Gawecka J.E., Geerts D., Koster J., Caliva M.J., Sulzmaier F.J., Opoku-Ansah J., Wada R.K., Bachmann A.S., Ramos J.W.
PEA15 impairs cell migration and correlates with clinical features predicting good prognosis in neuroblastoma.
Int. J. Cancer 131:1556-1568(2012)
PubMed=22460905; DOI=10.1038/nature11003; PMCID=PMC3320027
Barretina J.G., Caponigro G., Stransky N., Venkatesan K., Margolin A.A., Kim S., Wilson C.J., Lehar J., Kryukov G.V., Sonkin D., Reddy A., Liu M., Murray L., Berger M.F., Monahan J.E., Morais P., Meltzer J., Korejwa A., Jane-Valbuena J., Mapa F.A., Thibault J., Bric-Furlong E., Raman P., Shipway A., Engels I.H., Cheng J., Yu G.-Y.K., Yu J.-J., Aspesi P. Jr., de Silva M., Jagtap K., Jones M.D., Wang L., Hatton C., Palescandolo E., Gupta S., Mahan S., Sougnez C., Onofrio R.C., Liefeld T., MacConaill L.E., Winckler W., Reich M., Li N.-X., Mesirov J.P., Gabriel S.B., Getz G., Ardlie K., Chan V., Myer V.E., Weber B.L., Porter J., Warmuth M., Finan P., Harris J.L., Meyerson M.L., Golub T.R., Morrissey M.P., Sellers W.R., Schlegel R., Garraway L.A.
The Cancer Cell Line Encyclopedia enables predictive modelling of anticancer drug sensitivity.
Nature 483:603-607(2012)
PubMed=24466371; DOI=10.1593/tlo.13544; PMCID=PMC3890703
Loschmann N., Michaelis M., Rothweiler F., Zehner R., Cinatl J., Voges Y., Sharifi M., Riecken K., Meyer J., von Deimling A., Fichtner I., Ghafourian T., Westermann F., Cinatl J. Jr.
Testing of SNS-032 in a panel of human neuroblastoma cell lines with acquired resistance to a broad range of drugs.
Transl. Oncol. 6:685-696(2013)
PubMed=25485619; DOI=10.1038/nbt.3080
Klijn C., Durinck S., Stawiski E.W., Haverty P.M., Jiang Z.-S., Liu H.-B., Degenhardt J., Mayba O., Gnad F., Liu J.-F., Pau G., Reeder J., Cao Y., Mukhyala K., Selvaraj S.K., Yu M.-M., Zynda G.J., Brauer M.J., Wu T.D., Gentleman R.C., Manning G., Yauch R.L., Bourgon R., Stokoe D., Modrusan Z., Neve R.M., de Sauvage F.J., Settleman J., Seshagiri S., Zhang Z.-M.
A comprehensive transcriptional portrait of human cancer cell lines.
Nat. Biotechnol. 33:306-312(2015)
PubMed=25877200; DOI=10.1038/nature14397
Yu M., Selvaraj S.K., Liang-Chu M.M.Y., Aghajani S., Busse M., Yuan J., Lee G., Peale F.V., Klijn C., Bourgon R., Kaminker J.S., Neve R.M.
A resource for cell line authentication, annotation and quality control.
Nature 520:307-311(2015)
PubMed=25894527; DOI=10.1371/journal.pone.0121314; PMCID=PMC4404347
Bausch-Fluck D., Hofmann A., Bock T., Frei A.P., Cerciello F., Jacobs A., Moest H., Omasits U., Gundry R.L., Yoon C., Schiess R., Schmidt A., Mirkowska P., Hartlova A.S., Van Eyk J.E., Bourquin J.-P., Aebersold R., Boheler K.R., Zandstra P.W., Wollscheid B.
A mass spectrometric-derived cell surface protein atlas.
PLoS ONE 10:E0121314-E0121314(2015)
PubMed=26589293; DOI=10.1186/s13073-015-0240-5; PMCID=PMC4653878
Scholtalbers J., Boegel S., Bukur T., Byl M., Goerges S., Sorn P., Loewer M., Sahin U., Castle J.C.
TCLP: an online cancer cell line catalogue integrating HLA type, predicted neo-epitopes, virus and gene expression.
Genome Med. 7:118.1-118.7(2015)
PubMed=28350380; DOI=10.1038/sdata.2017.33; PMCID=PMC5369315
Harenza J.L., Diamond M.A., Adams R.N., Song M.M., Davidson H.L., Hart L.S., Dent M.H., Fortina P., Reynolds C.P., Maris J.M.
Transcriptomic profiling of 39 commonly-used neuroblastoma cell lines.
Sci. Data 4:170033-170033(2017)
PubMed=30894373; DOI=10.1158/0008-5472.CAN-18-2747; PMCID=PMC6445675
Dutil J., Chen Z.-H., Monteiro A.N.A., Teer J.K., Eschrich S.A.
An interactive resource to probe genetic diversity and estimated ancestry in cancer cell lines.
Cancer Res. 79:1263-1273(2019)"
Balaban-Malenbaum G.B., Gilbert F.
Double minute chromosomes and the homogeneously staining regions in chromosomes of a human neuroblastoma cell line.
Science 198:739-741(1977)
PubMed=327080; DOI=10.1093/jnci/59.1.221
Fogh J., Fogh J.M., Orfeo T.
One hundred and twenty-seven cultured human tumor cell lines producing tumors in nude mice.
J. Natl. Cancer Inst. 59:221-226(1977)
PubMed=833871; DOI=10.1093/jnci/58.2.209
Fogh J., Wright W.C., Loveless J.D.
Absence of HeLa cell contamination in 169 cell lines derived from human tumors.
J. Natl. Cancer Inst. 58:209-214(1977)
PubMed=922665; DOI=10.1002/1097-0142(197711)40:5<2256::AID-CNCR2820400536>3.0.CO;2-1
Brodeur G.M., Sekhon G.S., Goldstein M.N.
Chromosomal aberrations in human neuroblastomas.
Cancer 40:2256-2263(1977)
CLPUB00387
Coriell L.L., Greene A.E., Mulivor R.A.
The human genetic mutant cell repository: list of genetic variants, chromosomal aberrations and normal cell cultures submitted to the repository. 7th edition. October 1980.
(In misc. document) Institute for Medical Research (Camden, N.J.) NIH 80-2011; pp.1-254; National Institutes of Health; Bethesda; USA (1980)
PubMed=6935474; DOI=10.1093/jnci/66.2.239
Wright W.C., Daniels W.P., Fogh J.
Distinction of seventy-one cultured human tumor cell lines by polymorphic enzyme analysis.
J. Natl. Cancer Inst. 66:239-247(1981)
PubMed=7253718; DOI=10.1016/0047-6374(81)90027-0
Das N.K., Murphy D.G.
The National Institute on Aging repository cell cultures.
Mech. Ageing Dev. 16:1-17(1981)
PubMed=7459858
Rousset M., Zweibaum A., Fogh J.
Presence of glycogen and growth-related variations in 58 cultured human tumor cell lines of various tissue origins.
Cancer Res. 41:1165-1170(1981)
PubMed=7037175
Reynolds C.P., Reynolds D.A., Frenkel E.P., Smith R.G.
Selective toxicity of 6-hydroxydopamine and ascorbate for human neuroblastoma in vitro: a model for clearing marrow prior to autologous transplant.
Cancer Res. 42:1331-1336(1982)
PubMed=7139592; DOI=10.1016/0165-4608(82)90105-4
Gilbert F., Balaban-Malenbaum G.B., Moorhead P.S., Bianchi D., Schlesinger H.R.
Abnormalities of chromosome 1p in human neuroblastoma tumors and cell lines.
Cancer Genet. Cytogenet. 7:33-42(1982)
DOI=10.1016/B978-0-12-008304-6.50015-4
Biedler J.L., Meyers M.B., Spengler B.A.
Homogeneously staining regions and double minute chromosomes, prevalent cytogenetic abnormalities of human neuroblastoma cells.
(In book chapter) Advances in cellular neurobiology, Vol. 4; Fedoroff S., Hertz L. (eds.); pp.267-307; Academic Press; New York; USA (1983)
PubMed=6401685; DOI=10.1007/BF02617989
Halton D.M., Peterson W.D. Jr., Hukku B.
Cell culture quality control by rapid isoenzymatic characterization.
In Vitro 19:16-24(1983)
PubMed=6888561; DOI=10.1038/305245a0
Schwab M., Alitalo K., Klempnauer K.-H., Varmus H.E., Bishop J.M., Gilbert F., Brodeur G.M., Goldstein M.N., Trent J.M.
Amplified DNA with limited homology to myc cellular oncogene is shared by human neuroblastoma cell lines and a neuroblastoma tumour.
Nature 305:245-248(1983)
PubMed=3518877; DOI=10.3109/07357908609038260
Fogh J.
Human tumor lines for cancer research.
Cancer Invest. 4:157-184(1986)
PubMed=3698005
Bregman M.D., Funk C., Fukushima M.
Inhibition of human melanoma growth by prostaglandin A, D, and J analogues.
Cancer Res. 46:2740-2744(1986)
PubMed=2535691
Ciccarone V.C., Spengler B.A., Meyers M.B., Biedler J.L., Ross R.A.
Phenotypic diversification in human neuroblastoma cells: expression of distinct neural crest lineages.
Cancer Res. 49:219-225(1989)
PubMed=8221663
Komuro H., Hayashi Y., Kawamura M., Hayashi K., Kaneko Y., Kamoshita S., Hanada R., Yamamoto K., Hongo T., Yamada M., Tsuchida Y.
Mutations of the p53 gene are involved in Ewing's sarcomas but not in neuroblastomas.
Cancer Res. 53:5284-5288(1993)
PubMed=8490657; DOI=10.1038/ng0193-62
The I., Murthy A.E., Hannigan G.E., Jacoby L.B., Menon A.G., Gusella J.F., Bernards A.
Neurofibromatosis type 1 gene mutations in neuroblastoma.
Nat. Genet. 3:62-66(1993)
DOI=10.1016/B978-0-12-333530-2.50006-X
Israel M.A., Thiele C.J.
Tumor cell lines of the peripheral nervous system.
(In book chapter) Atlas of human tumor cell lines; Hay R.J., Park J.-G., Gazdar A.F. (eds.); pp.43-78; Academic Press; New York; USA (1994)
PubMed=7838528
Cheng N.C., Van Roy N., Chan A., Beitsma M., Westerveld A., Speleman F., Versteeg R.
Deletion mapping in neuroblastoma cell lines suggests two distinct tumor suppressor genes in the 1p35-36 region, only one of which is associated with N-myc amplification.
Oncogene 10:291-297(1995)
PubMed=8665486; DOI=10.1016/0304-3835(96)04250-4
Diccianni M.B., Chau L.S., Batova A., Vu T.Q., Yu A.L.-T.
The p16 and p18 tumor suppressor genes in neuroblastoma: implications for drug resistance.
Cancer Lett. 104:183-192(1996)
PubMed=9201287
Cinatl J. Jr., Hernaiz Driever P., Cinatl J., Ruckert D.G., Gumbel H.O.C., Rabenau H.F., Kornhuber B., Doerr H.-W.
Increased efficacy of aphidicolin killing of human neuroblastoma cells in vitro by encapsulation in liposomes.
Neoplasma 44:91-95(1997)
PubMed=9283597; DOI=10.1016/S0165-4608(96)00362-7
Van Roy N., Jauch A., Van Gele M., Laureys G., Versteeg R., De Paepe A., Cremer T., Speleman F.
Comparative genomic hybridization analysis of human neuroblastomas: detection of distal 1p deletions and further molecular genetic characterization of neuroblastoma cell lines.
Cancer Genet. Cytogenet. 97:135-142(1997)
PubMed=9516836; DOI=10.1016/S0959-8049(97)00319-5
Van Roy N., Laureys G., Van Gele M., Opdenakker G., Miura R., van der Drift P., Chan A., Versteeg R., Speleman F.
Analysis of 1;17 translocation breakpoints in neuroblastoma: implications for mapping of neuroblastoma genes.
Eur. J. Cancer 33:1974-1978(1997)
DOI=10.1007/0-306-46872-7_2
Thiele C.J.
Neuroblastoma.
(In book chapter) Human cell culture. Vol. 1. Cancer cell lines part 1; Masters J.R.W., Palsson B.O. (eds.); pp.21-53; Kluwer Academic Publishers; New York; USA (1999)
PubMed=11550280; DOI=10.1002/gcc.1174
Van Roy N., Van Limbergen H., Vandesompele J., Van Gele M., Poppe B., Salwen H.R., Laureys G., Manoel N., De Paepe A., Speleman F.
Combined M-FISH and CGH analysis allows comprehensive description of genetic alterations in neuroblastoma cell lines.
Genes Chromosomes Cancer 32:126-135(2001)
PubMed=11668190; DOI=10.1177/002215540104901105
Quentmeier H., Osborn M., Reinhardt J., Zaborski M., Drexler H.G.
Immunocytochemical analysis of cell lines derived from solid tumors.
J. Histochem. Cytochem. 49:1369-1378(2001)
PubMed=12210830; DOI=10.1002/jnr.10330
Yoshida S., Narita T., Taga T., Ohta S., Takeuchi Y.
Malignant rhabdoid tumor shows incomplete neural characteristics as revealed by expression of SNARE complex.
J. Neurosci. Res. 69:642-652(2002)
PubMed=12702577
Saito-Ohara F., Imoto I., Inoue J., Hosoi H., Nakagawara A., Sugimoto T., Inazawa J.
PPM1D is a potential target for 17q gain in neuroblastoma.
Cancer Res. 63:1876-1883(2003)
PubMed=15390183; DOI=10.1002/gcc.20096
Gebauer S., Yu A.L.-T., Omura-Minamisawa M., Batova A., Diccianni M.B.
Expression profiles and clinical relationships of ID2, CDKN1B, and CDKN2A in primary neuroblastoma.
Genes Chromosomes Cancer 41:297-308(2004)
PubMed=15892104; DOI=10.1002/gcc.20198
Mosse Y.P., Greshock J., Margolin A.A., Naylor T., Cole K.A., Khazi D., Hii G., Winter C., Shahzad S., Asziz M.U., Biegel J.A., Weber B.L., Maris J.M.
High-resolution detection and mapping of genomic DNA alterations in neuroblastoma.
Genes Chromosomes Cancer 43:390-403(2005)
PubMed=16524757; DOI=10.1016/j.biocel.2006.01.007
Fry D.G., Dayton B.D., Brodjian S.J., Ogiela C., Sidorowicz H., Frost L.J., McNally T., Reilly R.M., Collins C.A.
Characterization of a neuronal cell line expressing native human melanin-concentrating hormone receptor 1 (MCHR1).
Int. J. Biochem. Cell Biol. 38:1290-1299(2006)
PubMed=16822308; DOI=10.1186/1471-2407-6-177; PMCID=PMC1533846
Dam V., Morgan B.T., Mazanek P., Hogarty M.D.
Mutations in PIK3CA are infrequent in neuroblastoma.
BMC Cancer 6:177.1-177.10(2006)
PubMed=17974978; DOI=10.1158/0008-5472.CAN-06-4345
Xue C.-Y., Haber M., Flemming C., Marshall G.M., Lock R.B., MacKenzie K.L., Gurova K.V., Norris M.D., Gudkov A.V.
p53 determines multidrug sensitivity of childhood neuroblastoma.
Cancer Res. 67:10351-10360(2007)
PubMed=20655465; DOI=10.1016/j.cell.2010.06.004; PMCID=PMC2913027
Holzel M., Huang S.-D., Koster J., Ora I., Lakeman A., Caron H.N., Nijkamp W., Xie J., Callens T., Asgharzadeh S., Seeger R.C., Messiaen L.M., Versteeg R., Bernards R.
NF1 is a tumor suppressor in neuroblastoma that determines retinoic acid response and disease outcome.
Cell 142:218-229(2010)
PubMed=22213050; DOI=10.1002/ijc.27415; PMCID=PMC3757132
Gawecka J.E., Geerts D., Koster J., Caliva M.J., Sulzmaier F.J., Opoku-Ansah J., Wada R.K., Bachmann A.S., Ramos J.W.
PEA15 impairs cell migration and correlates with clinical features predicting good prognosis in neuroblastoma.
Int. J. Cancer 131:1556-1568(2012)
PubMed=22460905; DOI=10.1038/nature11003; PMCID=PMC3320027
Barretina J.G., Caponigro G., Stransky N., Venkatesan K., Margolin A.A., Kim S., Wilson C.J., Lehar J., Kryukov G.V., Sonkin D., Reddy A., Liu M., Murray L., Berger M.F., Monahan J.E., Morais P., Meltzer J., Korejwa A., Jane-Valbuena J., Mapa F.A., Thibault J., Bric-Furlong E., Raman P., Shipway A., Engels I.H., Cheng J., Yu G.-Y.K., Yu J.-J., Aspesi P. Jr., de Silva M., Jagtap K., Jones M.D., Wang L., Hatton C., Palescandolo E., Gupta S., Mahan S., Sougnez C., Onofrio R.C., Liefeld T., MacConaill L.E., Winckler W., Reich M., Li N.-X., Mesirov J.P., Gabriel S.B., Getz G., Ardlie K., Chan V., Myer V.E., Weber B.L., Porter J., Warmuth M., Finan P., Harris J.L., Meyerson M.L., Golub T.R., Morrissey M.P., Sellers W.R., Schlegel R., Garraway L.A.
The Cancer Cell Line Encyclopedia enables predictive modelling of anticancer drug sensitivity.
Nature 483:603-607(2012)
PubMed=24466371; DOI=10.1593/tlo.13544; PMCID=PMC3890703
Loschmann N., Michaelis M., Rothweiler F., Zehner R., Cinatl J., Voges Y., Sharifi M., Riecken K., Meyer J., von Deimling A., Fichtner I., Ghafourian T., Westermann F., Cinatl J. Jr.
Testing of SNS-032 in a panel of human neuroblastoma cell lines with acquired resistance to a broad range of drugs.
Transl. Oncol. 6:685-696(2013)
PubMed=25485619; DOI=10.1038/nbt.3080
Klijn C., Durinck S., Stawiski E.W., Haverty P.M., Jiang Z.-S., Liu H.-B., Degenhardt J., Mayba O., Gnad F., Liu J.-F., Pau G., Reeder J., Cao Y., Mukhyala K., Selvaraj S.K., Yu M.-M., Zynda G.J., Brauer M.J., Wu T.D., Gentleman R.C., Manning G., Yauch R.L., Bourgon R., Stokoe D., Modrusan Z., Neve R.M., de Sauvage F.J., Settleman J., Seshagiri S., Zhang Z.-M.
A comprehensive transcriptional portrait of human cancer cell lines.
Nat. Biotechnol. 33:306-312(2015)
PubMed=25877200; DOI=10.1038/nature14397
Yu M., Selvaraj S.K., Liang-Chu M.M.Y., Aghajani S., Busse M., Yuan J., Lee G., Peale F.V., Klijn C., Bourgon R., Kaminker J.S., Neve R.M.
A resource for cell line authentication, annotation and quality control.
Nature 520:307-311(2015)
PubMed=25894527; DOI=10.1371/journal.pone.0121314; PMCID=PMC4404347
Bausch-Fluck D., Hofmann A., Bock T., Frei A.P., Cerciello F., Jacobs A., Moest H., Omasits U., Gundry R.L., Yoon C., Schiess R., Schmidt A., Mirkowska P., Hartlova A.S., Van Eyk J.E., Bourquin J.-P., Aebersold R., Boheler K.R., Zandstra P.W., Wollscheid B.
A mass spectrometric-derived cell surface protein atlas.
PLoS ONE 10:E0121314-E0121314(2015)
PubMed=26589293; DOI=10.1186/s13073-015-0240-5; PMCID=PMC4653878
Scholtalbers J., Boegel S., Bukur T., Byl M., Goerges S., Sorn P., Loewer M., Sahin U., Castle J.C.
TCLP: an online cancer cell line catalogue integrating HLA type, predicted neo-epitopes, virus and gene expression.
Genome Med. 7:118.1-118.7(2015)
PubMed=28350380; DOI=10.1038/sdata.2017.33; PMCID=PMC5369315
Harenza J.L., Diamond M.A., Adams R.N., Song M.M., Davidson H.L., Hart L.S., Dent M.H., Fortina P., Reynolds C.P., Maris J.M.
Transcriptomic profiling of 39 commonly-used neuroblastoma cell lines.
Sci. Data 4:170033-170033(2017)
PubMed=30894373; DOI=10.1158/0008-5472.CAN-18-2747; PMCID=PMC6445675
Dutil J., Chen Z.-H., Monteiro A.N.A., Teer J.K., Eschrich S.A.
An interactive resource to probe genetic diversity and estimated ancestry in cancer cell lines.
Cancer Res. 79:1263-1273(2019)"
文献支持
IMR-32人神经母细胞瘤细胞种子库|送STR图谱
¥850 - 2150